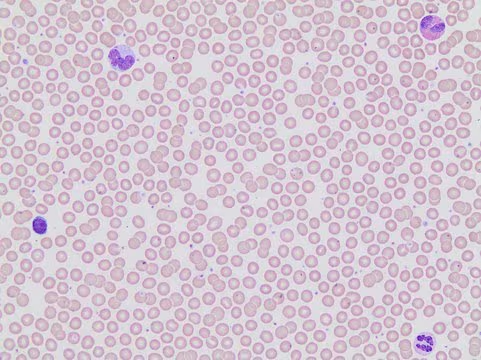
Automated Wright Stain Set, 1 X 1 set (WSHT-1SET)

Bulk Discount Available!

Automated Wright Stain Set, 1 X 1 set (WSHT-1SET)
MilliporeSigma® (Sigma-Aldrich)
$121.00
Earn points on this purchase